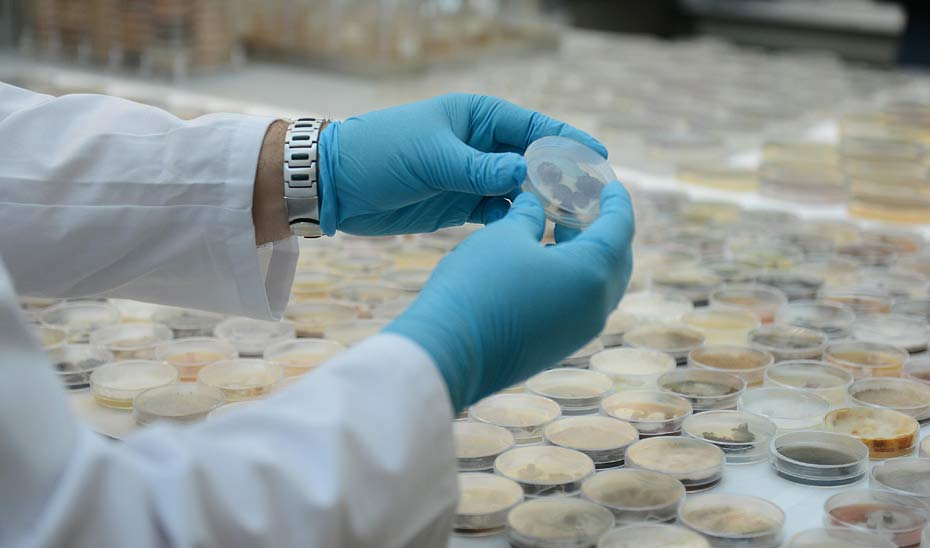
La inversión en I+D en Andalucía crece un 11,03% en 2022 La inversión en I+D en Andalucía crece un 11,03% en 2022. Imagen: https://www.juntadeandalucia.es/

La inversión en I+D en Andalucía alcanzó los 1.890,6 millones de euros en 2022, lo que supone un incremento del 11,03% con respecto a 2021, más del doble de la tasa de crecimiento experimentada en ese ejercicio, en el que se registró un montante de 1.703 millones y una evolución positiva del 4,7%. Esa subida es, además, la mayor desde el año 2007. Así se recoge en el informe sobre ‘Actividades de I+D en Andalucía 2022’, elaborado por la Agencia para la Calidad Científica y Universitaria de Andalucía (ACCUA), adscrita a la Consejería de Universidad, Investigación e Innovación, a partir de los datos publicados por el Instituto Nacional de Estadística (INE).
Esa partida se traduce en 187,9 millones de euros más en relación con 2021 y en 411,15 millones con respecto al ejercicio 2018, lo que representa un alza del 27,8% desde el inicio de la anterior legislatura. Asimismo, los 1.890,6 millones suponen el 9,8% del gasto total nacional en I+D y consolidan a Andalucía como la tercera comunidad del país.
Como ya ocurrió en 2021, en Andalucía el esfuerzo inversor en investigación y desarrollo procede, mayoritariamente, del sector público (Administración pública y enseñanza superior), que continúa actuando como activo tractor de la inversión regional en I+D. Aportó el 63,9% de los recursos invertidos, lo que equivale a 1.209 millones de euros, frente al 36,1% del segmento privado, esto es 681,6 millones, que engloba a empresas e instituciones privadas sin fines de lucro.
En 2022, la inversión en investigación y desarrollo se ha incrementado en un 9,2% en el sector público, lo que supone la mayor subida en catorce años. Los anteriores incrementos se produjeron en 2021, apuntándose entonces un 7,08%, en 2020, con un 5,87%, y en 2019, con un 5,28%. Atendiendo a ello, los cuatro mayores crecimientos en este ámbito desde 2008 se han dado en el Gobierno de Juanma Moreno. Ese mejor comportamiento observado desde 2019 en la esfera pública está sustentado, en gran medida, en el compromiso de la Administración pública, y más especialmente del Ejecutivo autonómico, por reforzar y reactivar el sistema andaluz del conocimiento, incrementando los recursos públicos puestos a disposición de los diferentes agentes, después de casi una década en la que se han producido importantes caídas en el gasto en I+D.
La inversión media anual en la décima legislatura, periodo 2015-2018, fue de 1.434,7 millones de euros, mientras que, en los primeros cuatro años de gobierno de Juanma Moreno, 2019-2022, el desembolso subió hasta los 1.689,7, lo que conlleva un incremento del 17,8%.
Por su parte, el alza experimentada por el ámbito privado se cuantifica en un 14,41%, un ascenso de doble dígito que no se producía desde 2010.
Inversión regional en I+D por sectores
Por sectores diferenciados, en 2022 la inversión regional en I+D la encabeza en la comunidad el sector de la enseñanza superior, con 817 millones y el 43,2% del total del gasto.
Les siguen las empresas, con 676,4 millones (35,8%); las administraciones públicas, con 392,4 millones (20,8%); y, por último, las instituciones privadas sin fines de lucro, con 5,2 millones (0,27%).
Recursos humanos de I+D
En relación con el potencial humano en materia de investigación, Andalucía sigue siendo la tercera región con mayor número de personas dedicadas a actividades de I+D, alcanzando las 28.518 (equivalencia en jornada completa) entre personal investigador y técnico y auxiliar. Este indicador se ha visto incrementado en 2022 en 1.474,9 personas, un 5,45% más que en el año anterior, y en 3.787 personas desde 2018.
El personal investigador en Andalucía representa el 10,3% del conjunto nacional. La mayoría de este colectivo desempeña su labor en el sector público (74,0%), esencialmente en la universidad, y el resto, el 26,0%, en el segmento privado.
Brecha de género
En Andalucía, el personal de I+D masculino supone el 58,43% (16.663), mientras que el femenino representa el 41,57% (11.855), lo que implica una congelación de la brecha de género respecto a la situación de 2021, según detalla una nota de prensa de la Junta de Andalucía recogida por Granada Actualidad.
Estas diferencias se derivan principalmente del sector privado, ya que el porcentaje de mujeres investigadoras en el sector público en Andalucía alcanza el valor de 45,5% en 2022, mientras que en el sector privado este porcentaje es del 28,0%. El total de mujeres dedicadas a I+D, incluyendo tanto investigadoras como técnicas, es del 47,6% en el sector público y del 29,2% en la esfera privada.